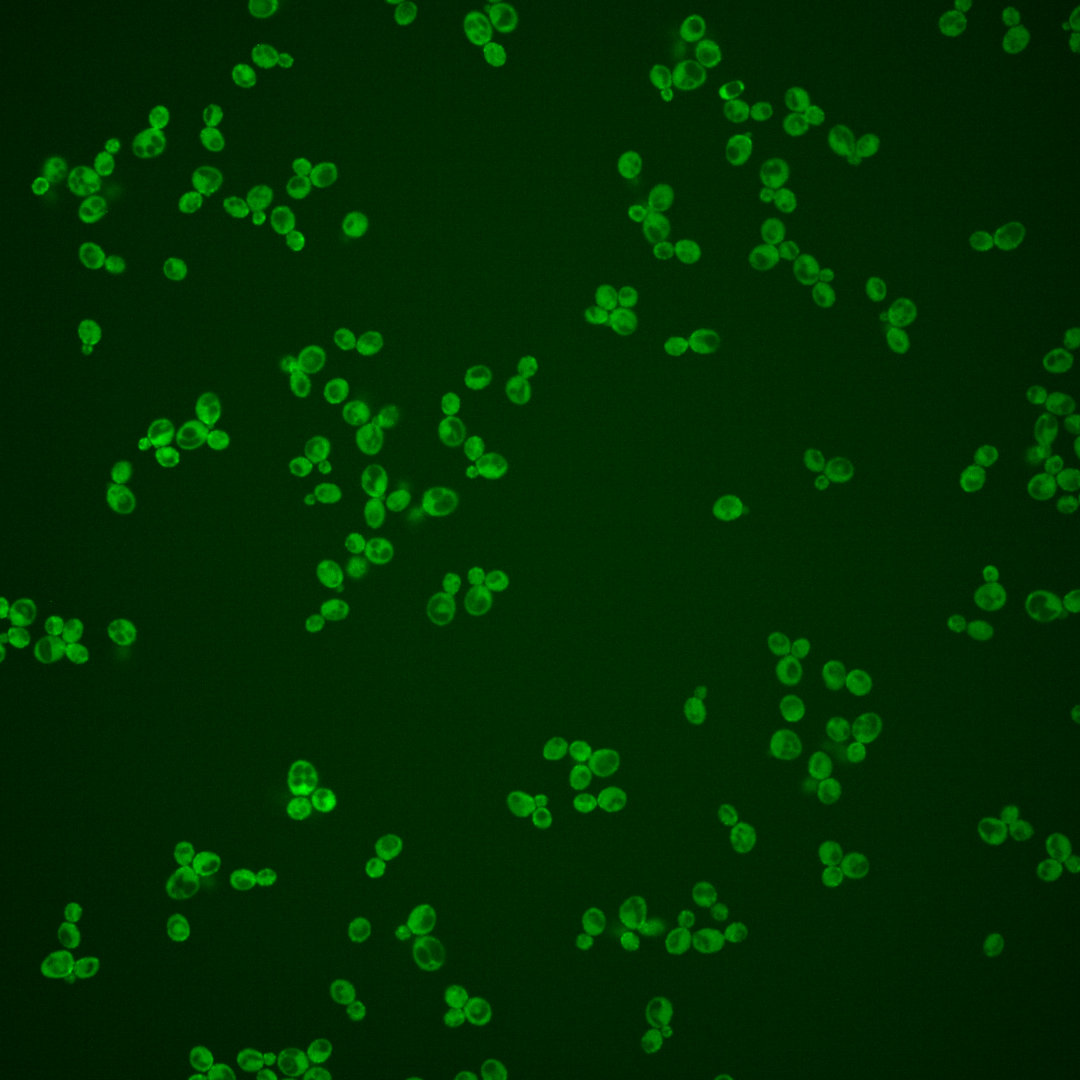
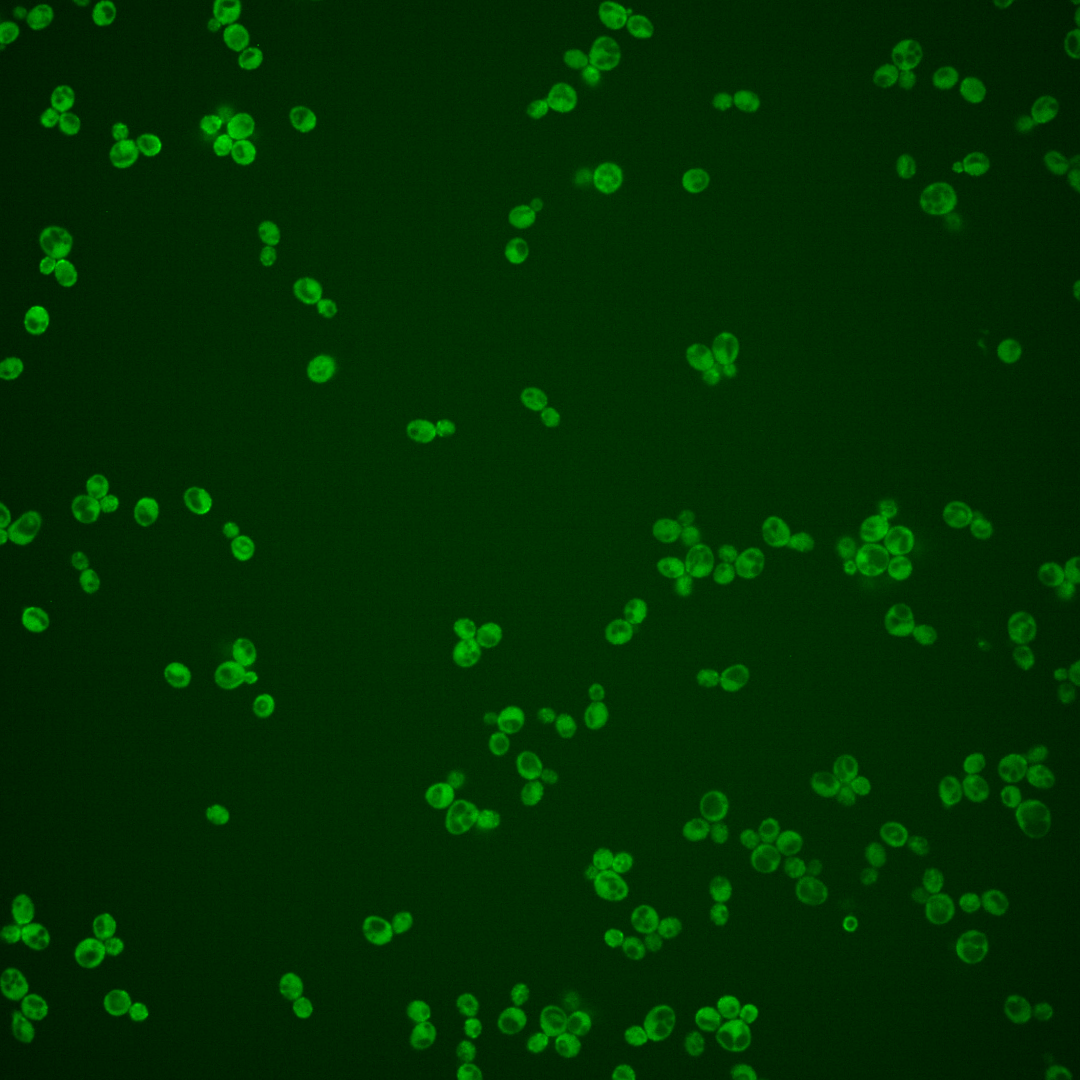
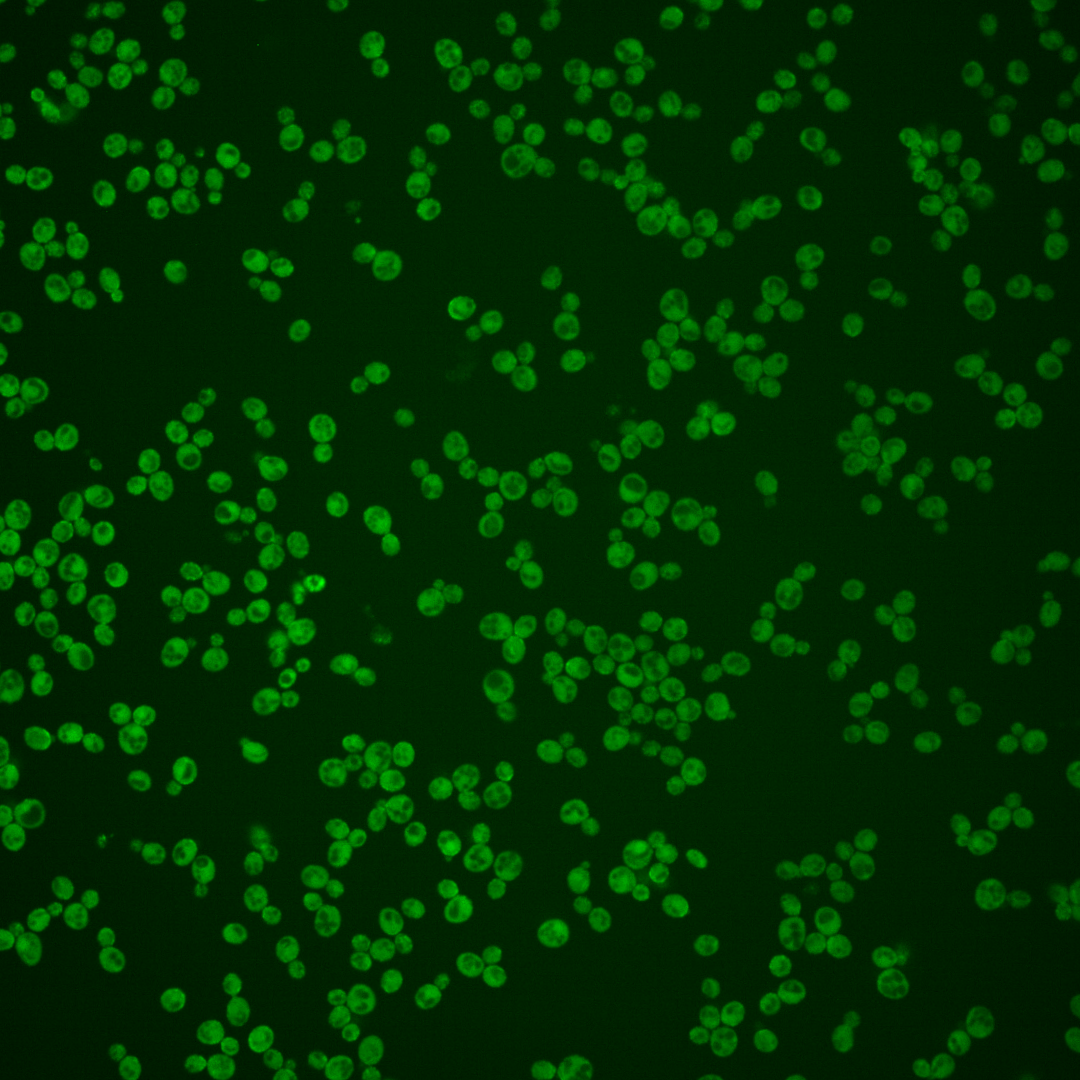
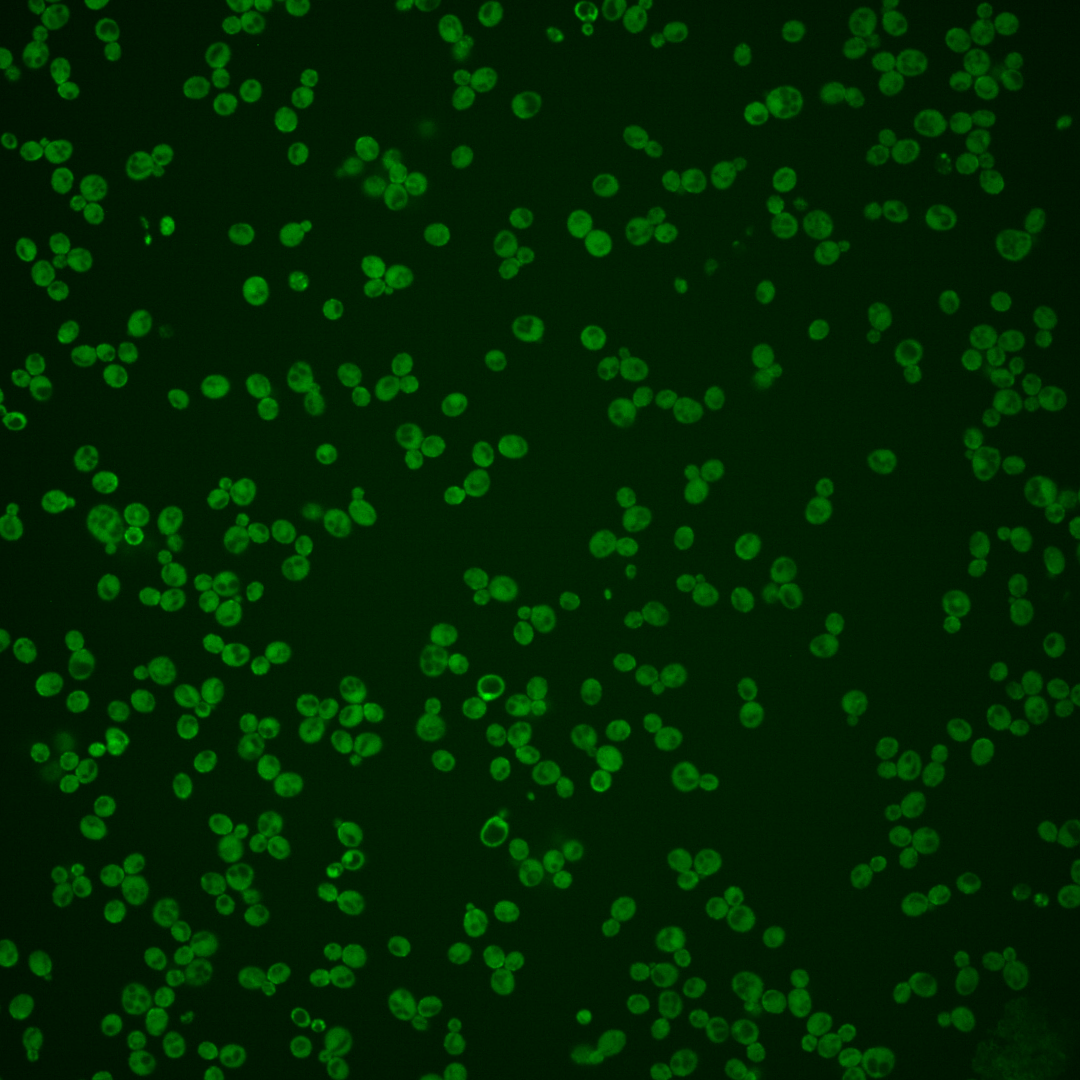
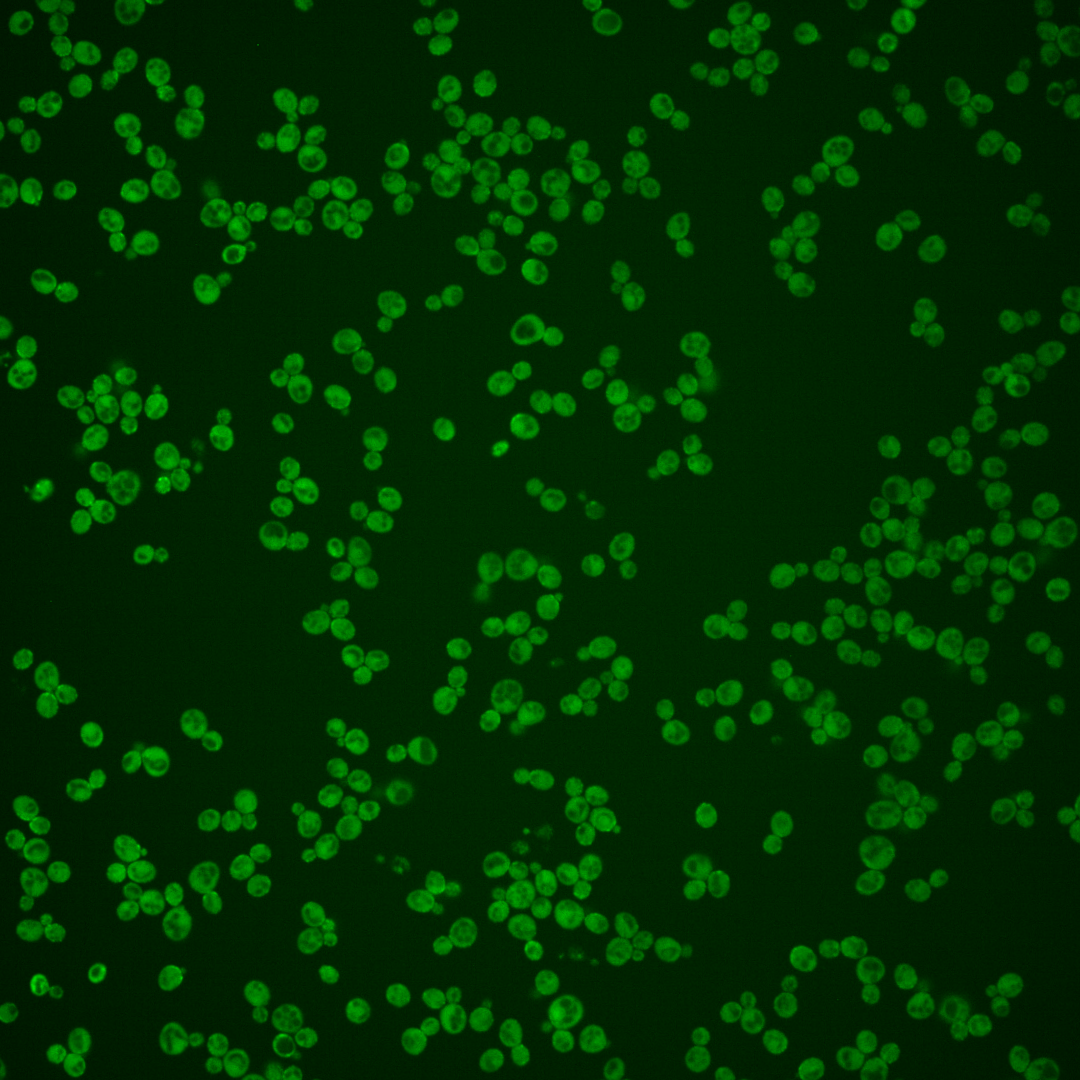

| Standard name | |
|---|---|
| Human Ortholog | |
| Description | Protein involved in microtubule morphogenesis; required for protection from excess free beta-tubulin; proposed to be involved the folding of beta-tubulin; similar to mouse beta-tubulin cofactor A; protein abundance increases in response to DNA replication stress |
Micrographs




















































































Sub-cellular Localization
Yeast GFP Assignment
Protein Abundance
Localization Change
External localization resources
| ensLOC | DeepLoc | |||||||||||||||||||||||
|---|---|---|---|---|---|---|---|---|---|---|---|---|---|---|---|---|---|---|---|---|---|---|---|---|
| Localization | WT1 | WT2 | WT3 | RAP60 | RAP140 | RAP220 | RAP300 | RAP380 | RAP460 | RAP540 | RAP620 | RAP700 | HU80 | HU120 | HU160 | rpd3Δ_1 | rpd3Δ_2 | rpd3Δ_3 | WT1 | WT2 | WT3 | AF100 | AF140 | AF180 |
| Cortical Patches | 28 | 47 | 7 | 39 | 60 | 57 | – | 29 | 11 | 20 | 16 | 14 | 13 | 36 | 35 | 2 | 1 | 1 | 40 | 65 | 23 | 14 | 24 | 36 |
| Bud | 16 | 20 | 16 | 18 | 38 | 20 | – | 17 | 26 | 27 | 9 | 21 | 5 | 13 | 19 | 2 | 1 | 4 | 8 | 8 | 2 | 0 | 3 | 5 |
| Bud Neck | 0 | 0 | 0 | 0 | 0 | 0 | – | 0 | 0 | 0 | 0 | 0 | 0 | 0 | 1 | 0 | 0 | 1 | 43 | 31 | 18 | 10 | 15 | 23 |
| Bud Site | 2 | 0 | 2 | 1 | 4 | 1 | – | 1 | 1 | 0 | 0 | 3 | 0 | 0 | 0 | 0 | 0 | 0 | – | – | – | – | – | – |
| Cell Periphery | 138 | 180 | 23 | 95 | 101 | 106 | – | 65 | 73 | 95 | 79 | 93 | 142 | 275 | 253 | 15 | 4 | 26 | 55 | 89 | 16 | 9 | 28 | 49 |
| Cytoplasm | 309 | 183 | 107 | 146 | 174 | 161 | – | 267 | 241 | 268 | 178 | 257 | 150 | 238 | 178 | 31 | 32 | 43 | 245 | 137 | 71 | 95 | 177 | 210 |
| Endoplasmic Reticulum | 26 | 33 | 6 | 27 | 63 | 80 | – | 76 | 32 | 47 | 35 | 38 | 18 | 22 | 40 | 2 | 1 | 1 | 48 | 45 | 13 | 13 | 30 | 31 |
| Endosome | 0 | 0 | 0 | 1 | 11 | 0 | – | 3 | 2 | 0 | 0 | 0 | 0 | 0 | 0 | 0 | 1 | 0 | 2 | 1 | 1 | 0 | 0 | 3 |
| Golgi | 2 | 0 | 0 | 1 | 0 | 0 | – | 0 | 0 | 0 | 0 | 0 | 0 | 0 | 0 | 0 | 0 | 0 | 1 | 1 | 0 | 0 | 0 | 3 |
| Mitochondria | 7 | 2 | 6 | 23 | 20 | 44 | – | 65 | 113 | 95 | 82 | 150 | 0 | 1 | 0 | 1 | 0 | 0 | 5 | 4 | 6 | 1 | 1 | 5 |
| Nucleus | 5 | 5 | 1 | 1 | 2 | 1 | – | 0 | 0 | 1 | 0 | 2 | 1 | 2 | 2 | 0 | 2 | 3 | 1 | 0 | 0 | 0 | 0 | 0 |
| Nuclear Periphery | 0 | 1 | 0 | 2 | 0 | 0 | – | 0 | 1 | 2 | 1 | 1 | 0 | 0 | 1 | 0 | 0 | 0 | 0 | 1 | 0 | 0 | 0 | 0 |
| Nucleolus | 0 | 0 | 0 | 0 | 0 | 0 | – | 1 | 0 | 1 | 0 | 0 | 0 | 0 | 0 | 0 | 0 | 0 | 0 | 0 | 0 | 0 | 0 | 0 |
| Peroxisomes | 0 | 0 | 0 | 0 | 1 | 1 | – | 0 | 0 | 0 | 0 | 0 | 0 | 0 | 0 | 0 | 0 | 0 | 0 | 0 | 0 | 0 | 0 | 0 |
| SpindlePole | 0 | 0 | 1 | 0 | 2 | 0 | – | 0 | 0 | 0 | 0 | 0 | 0 | 0 | 1 | 0 | 1 | 0 | 0 | 0 | 0 | 0 | 0 | 0 |
| Vac/Vac Membrane | 0 | 1 | 1 | 0 | 16 | 4 | – | 14 | 22 | 14 | 2 | 8 | 0 | 0 | 1 | 1 | 2 | 0 | 2 | 6 | 6 | 1 | 3 | 6 |
| Unique Cell Count | 404 | 341 | 132 | 246 | 352 | 337 | 430 | 396 | 434 | 307 | 445 | 233 | 402 | 378 | 39 | 39 | 62 | 458 | 396 | 167 | 149 | 286 | 377 | |
| Labelled Cell Count | 533 | 472 | 170 | 354 | 492 | 475 | 538 | 522 | 570 | 402 | 587 | 329 | 587 | 531 | 54 | 45 | 79 | 458 | 396 | 167 | 149 | 286 | 377 | |
Yeast GFP Assignment
Protein Abundance
| Screen | WT1 | WT2 | WT3 | RAP60 | RAP140 | RAP220 | RAP300 | RAP380 | RAP460 | RAP540 | RAP620 | RAP700 | HU80 | HU120 | HU160 | rpd3Δ_1 | rpd3Δ_2 | rpd3Δ_3 | AF100 | AF140 | AF180 |
|---|---|---|---|---|---|---|---|---|---|---|---|---|---|---|---|---|---|---|---|---|---|
| Mean Cell GFP Intensity (1e-4) | 9.1 | 11.5 | 6.1 | 7.3 | 8.1 | 7.5 | – | 7.2 | 6.5 | 6.6 | 6.4 | 6.2 | 9.9 | 10.4 | 10.5 | 11.3 | 10.2 | 11.8 | 9.0 | 9.7 | 9.6 |
| Std Deviation (1e-4) | 1.5 | 1.5 | 1.3 | 1.6 | 1.3 | 1.5 | – | 1.3 | 1.4 | 1.3 | 1.2 | 1.2 | 1.4 | 1.5 | 1.7 | 2.7 | 3.5 | 3.2 | 1.3 | 1.5 | 2.0 |
| Intensity Change (Log2) | – | – | – | 0.27 | 0.43 | 0.31 | – | 0.24 | 0.09 | 0.13 | 0.08 | 0.05 | 0.71 | 0.78 | 0.8 | 0.9 | 0.75 | 0.97 | 0.58 | 0.68 | 0.66 |
Localization Change
| Localization | RAP60 | RAP140 | RAP220 | RAP300 | RAP380 | RAP460 | RAP540 | RAP620 | RAP700 | HU80 | HU120 | HU160 | rpd3Δ_1 | rpd3Δ_2 | rpd3Δ_3 |
|---|---|---|---|---|---|---|---|---|---|---|---|---|---|---|---|
| Cortical Patches | 3.0 | 3.3 | 3.3 | – | 0.6 | 0 | -0.3 | 0 | 0 | 0.1 | 1.3 | 1.4 | 0 | 0 | 0 |
| Bud | -1.6 | -0.4 | -2.3 | – | -3.5 | -2.0 | -2.2 | -3.8 | -3.0 | -3.9 | -3.9 | -2.8 | 0 | 0 | -1.2 |
| Bud Neck | 0 | 0 | 0 | – | 0 | 0 | 0 | 0 | 0 | 0 | 0 | 0 | 0 | 0 | 0 |
| Bud Site | 0 | 0 | 0 | – | 0 | 0 | 0 | 0 | 0 | 0 | 0 | 0 | 0 | 0 | 0 |
| Cell Periphery | 4.2 | 2.5 | 3.1 | – | -0.6 | 0.3 | 1.1 | 1.9 | 0.9 | 8.0 | 10.2 | 9.8 | 2.8 | -1.1 | 3.7 |
| Cytoplasm | -4.3 | -6.3 | -6.6 | – | -4.0 | -4.2 | -4.1 | -4.6 | -4.9 | -3.4 | -4.6 | -6.8 | -0.2 | 0.1 | -1.8 |
| Endoplasmic Reticulum | 2.1 | 3.7 | 4.8 | – | 3.7 | 1.4 | 2.2 | 2.3 | 1.5 | 1.2 | 0.4 | 2.1 | 0 | 0 | 0 |
| Endosome | 0 | 0 | 0 | – | 0 | 0 | 0 | 0 | 0 | 0 | 0 | 0 | 0 | 0 | 0 |
| Golgi | 0 | 0 | 0 | – | 0 | 0 | 0 | 0 | 0 | 0 | 0 | 0 | 0 | 0 | 0 |
| Mitochondria | 1.7 | 0.5 | 2.7 | – | 3.2 | 5.7 | 4.6 | 5.3 | 6.6 | 0 | 0 | 0 | 0 | 0 | 0 |
| Nucleus | 0 | 0 | 0 | – | 0 | 0 | 0 | 0 | 0 | 0 | 0 | 0 | 0 | 0 | 0 |
| Nuclear Periphery | 0 | 0 | 0 | – | 0 | 0 | 0 | 0 | 0 | 0 | 0 | 0 | 0 | 0 | 0 |
| Nucleolus | 0 | 0 | 0 | – | 0 | 0 | 0 | 0 | 0 | 0 | 0 | 0 | 0 | 0 | 0 |
| Peroxisomes | 0 | 0 | 0 | – | 0 | 0 | 0 | 0 | 0 | 0 | 0 | 0 | 0 | 0 | 0 |
| SpindlePole | 0 | 0 | 0 | – | 0 | 0 | 0 | 0 | 0 | 0 | 0 | 0 | 0 | 0 | 0 |
| Vacuole | 0 | 0 | 0 | – | 0 | 2.3 | 0 | 0 | 0 | 0 | 0 | 0 | 0 | 0 | 0 |
External localization resources
Images






























Protein Concentration and Protein Localization Data
| R1 | R2 | R3 | ||||||||||||||||
|---|---|---|---|---|---|---|---|---|---|---|---|---|---|---|---|---|---|---|
| G1 Pre-START | G1 Post-START | S/G2 | Metaphase | Anaphase | Telophase | G1 Pre-START | G1 Post-START | S/G2 | Metaphase | Anaphase | Telophase | G1 Pre-START | G1 Post-START | S/G2 | Metaphase | Anaphase | Telophase | |
| Concentration | 6.3552 | 6.8482 | 6.4245 | 6.0996 | 5.7983 | 6.3329 | 5.2082 | 6.5886 | 5.6194 | 4.9733 | 4.6591 | 6.0101 | 7.9511 | 8.5139 | 8.1206 | 8.5028 | 7.9106 | 8.2343 |
| Actin | 0.0216 | 0.0153 | 0.0272 | 0.0217 | 0.0688 | 0.0267 | 0.0748 | 0.0137 | 0.0687 | 0.0852 | 0.1211 | 0.0247 | 0.0241 | 0.0213 | 0.0423 | 0.0423 | 0.0592 | 0.0199 |
| Bud | 0.0012 | 0.0029 | 0.0046 | 0.0056 | 0.0057 | 0.0015 | 0.0019 | 0.0008 | 0.0061 | 0.0052 | 0.0033 | 0.0013 | 0.0006 | 0.002 | 0.0053 | 0.0032 | 0.0009 | 0.001 |
| Bud Neck | 0.0113 | 0.0055 | 0.013 | 0.0122 | 0.0183 | 0.0586 | 0.0083 | 0.0093 | 0.0134 | 0.0156 | 0.0099 | 0.0381 | 0.0075 | 0.0039 | 0.0177 | 0.0133 | 0.0059 | 0.0415 |
| Bud Periphery | 0.0071 | 0.0075 | 0.0271 | 0.0306 | 0.0431 | 0.015 | 0.0046 | 0.0018 | 0.0361 | 0.0241 | 0.014 | 0.009 | 0.0034 | 0.0035 | 0.0212 | 0.0276 | 0.0056 | 0.0094 |
| Bud Site | 0.0206 | 0.0974 | 0.0364 | 0.0104 | 0.008 | 0.0037 | 0.0168 | 0.0737 | 0.0345 | 0.0073 | 0.0046 | 0.0021 | 0.009 | 0.0796 | 0.0175 | 0.0018 | 0.0031 | 0.0021 |
| Cell Periphery | 0.2675 | 0.1273 | 0.1514 | 0.1016 | 0.1078 | 0.1791 | 0.1117 | 0.0551 | 0.0901 | 0.1105 | 0.0485 | 0.1085 | 0.216 | 0.0507 | 0.0798 | 0.0656 | 0.109 | 0.0993 |
| Cytoplasm | 0.5729 | 0.7104 | 0.7029 | 0.7066 | 0.6988 | 0.6755 | 0.6333 | 0.8308 | 0.6486 | 0.6653 | 0.5471 | 0.7563 | 0.683 | 0.8253 | 0.7932 | 0.7991 | 0.7849 | 0.7913 |
| Cytoplasmic Foci | 0.0054 | 0.0051 | 0.0019 | 0.0315 | 0.0043 | 0.0019 | 0.0191 | 0.0016 | 0.0132 | 0.0057 | 0.0203 | 0.0038 | 0.0041 | 0.0019 | 0.002 | 0.0026 | 0.0017 | 0.0012 |
| Eisosomes | 0.0062 | 0.0008 | 0.0011 | 0.0004 | 0.0015 | 0.0011 | 0.0012 | 0.0005 | 0.0008 | 0.0008 | 0.005 | 0.0004 | 0.0015 | 0.0001 | 0.0003 | 0.0002 | 0.0006 | 0.0003 |
| Endoplasmic Reticulum | 0.0385 | 0.0096 | 0.0166 | 0.0146 | 0.0125 | 0.0287 | 0.0267 | 0.0074 | 0.0154 | 0.0122 | 0.021 | 0.0155 | 0.0331 | 0.0054 | 0.0129 | 0.0343 | 0.0198 | 0.0287 |
| Endosome | 0.006 | 0.0031 | 0.0022 | 0.0195 | 0.0017 | 0.0009 | 0.0244 | 0.0003 | 0.0267 | 0.0056 | 0.0362 | 0.0069 | 0.003 | 0.0005 | 0.0009 | 0.0011 | 0.0004 | 0.0005 |
| Golgi | 0.0045 | 0.0035 | 0.0022 | 0.0104 | 0.004 | 0.0014 | 0.0214 | 0.0011 | 0.0137 | 0.012 | 0.0543 | 0.0061 | 0.0027 | 0.0011 | 0.0016 | 0.001 | 0.004 | 0.0012 |
| Lipid Particles | 0.0087 | 0.0042 | 0.0014 | 0.003 | 0.0074 | 0.0015 | 0.0095 | 0.0009 | 0.0094 | 0.0048 | 0.0296 | 0.0024 | 0.0027 | 0.0007 | 0.0009 | 0.003 | 0.0021 | 0.0008 |
| Mitochondria | 0.0043 | 0.0002 | 0.0009 | 0.004 | 0.0004 | 0.0001 | 0.0123 | 0 | 0.0058 | 0.0346 | 0.0327 | 0.0163 | 0.0008 | 0.0001 | 0.0001 | 0.0001 | 0.0001 | 0.0002 |
| None | 0.01 | 0.0027 | 0.0017 | 0.0167 | 0.0067 | 0.0007 | 0.011 | 0.0012 | 0.0022 | 0.0018 | 0.0015 | 0.0009 | 0.0026 | 0.0017 | 0.0012 | 0.0014 | 0.0004 | 0.0005 |
| Nuclear Periphery | 0.0031 | 0.0006 | 0.0032 | 0.0008 | 0.0006 | 0.0006 | 0.0039 | 0.0003 | 0.0041 | 0.0009 | 0.011 | 0.0016 | 0.0015 | 0.0004 | 0.0006 | 0.0008 | 0.0004 | 0.0004 |
| Nucleolus | 0.0007 | 0.0001 | 0.0002 | 0.0002 | 0.0001 | 0.0001 | 0.0005 | 0 | 0.0002 | 0.0001 | 0.0006 | 0.0001 | 0.0001 | 0 | 0 | 0 | 0 | 0 |
| Nucleus | 0.0017 | 0.001 | 0.0032 | 0.001 | 0.0005 | 0.0005 | 0.0026 | 0.0004 | 0.0011 | 0.0006 | 0.0074 | 0.0016 | 0.0008 | 0.0005 | 0.0006 | 0.0005 | 0.0003 | 0.0004 |
| Peroxisomes | 0.0006 | 0.0002 | 0.0002 | 0.0038 | 0.0064 | 0.0001 | 0.0062 | 0 | 0.0051 | 0.0042 | 0.0177 | 0.0018 | 0.0004 | 0.0001 | 0.0001 | 0.0001 | 0 | 0 |
| Punctate Nuclear | 0.0014 | 0.0002 | 0.0003 | 0.0011 | 0.0009 | 0.0001 | 0.0039 | 0.0001 | 0.0007 | 0.0003 | 0.0009 | 0.0005 | 0.0005 | 0.0001 | 0.0001 | 0.0003 | 0 | 0 |
| Vacuole | 0.0058 | 0.0024 | 0.0022 | 0.0039 | 0.0022 | 0.0022 | 0.0047 | 0.0006 | 0.0031 | 0.0029 | 0.0088 | 0.0016 | 0.0026 | 0.0011 | 0.0018 | 0.0017 | 0.0015 | 0.0012 |
| Vacuole Periphery | 0.0007 | 0.0001 | 0.0002 | 0.0005 | 0.0001 | 0.0001 | 0.0011 | 0 | 0.001 | 0.0004 | 0.0046 | 0.0004 | 0.0002 | 0 | 0.0001 | 0.0001 | 0 | 0.0001 |
Sequencing Data
| R1 | R2 | |||||||||
|---|---|---|---|---|---|---|---|---|---|---|
| G1 Post-START | S/G2 | Metaphase | Anaphase | Telophase | G1 Post-START | S/G2 | Metaphase | Anaphase | Telophase | |
| Gene Expression | 46.4049 | 43.0195 | 27.362 | 60.3743 | 33.4255 | 54.9679 | 51.2643 | 39.8424 | 57.4665 | 55.5557 |
| Translational Efficiency | 3.336 | 3.5092 | 5.7244 | 2.0391 | 3.6324 | 3.1164 | 2.9617 | 3.8978 | 2.8803 | 2.5265 |
Hit Data
| Dataset | Hit |
|---|---|
| Protein Concentration | ✘ |
| Protein Localization | ✘ |
| Gene Expression | ✘ |
| Translational Efficiency | ✘ |
Micrographs
































Cell Count
| R1 | R2 | R1 & R2 | |||||||||
|---|---|---|---|---|---|---|---|---|---|---|---|
| WT | UBP2 | UBP14 | UBP2UBP14 | WT | UBP2 | UBP14 | UBP2UBP14 | WT | UBP2 | UBP14 | UBP2UBP14 |
| 68 | 1256 | 1220 | 494 | 587 | 1835 | 1874 | 1297 | 655 | 3091 | 3094 | 1791 |
Protein Abundance
| R1 | R2 | R1 & R2 | ||||||||||
|---|---|---|---|---|---|---|---|---|---|---|---|---|
| WT | UBP2 | UBP14 | UBP2UBP14 | WT | UBP2 | UBP14 | UBP2UBP14 | WT | UBP2 | UBP14 | UBP2UBP14 | |
| Mean | 849.63 | 959.95 | 1127.27 | 1478.83 | 925.59 | 1019.31 | 1270.84 | 1340.05 | 917.70 | 995.19 | 1214.23 | 1378.33 |
| Standard Deviation | 113.68 | 147.71 | 196.47 | 243.69 | 125.77 | 138.81 | 165.95 | 215.21 | 126.71 | 145.45 | 191.89 | 231.88 |
| Intensity Change Log 2 | — | 0.176125 | 0.407926 | 0.799550 | — | 0.139148 | 0.457337 | 0.533842 | — | 0.156963 | 0.433900 | 0.667124 |
Localization Score (DeepLoc)
| R1 | R2 | R1 & R2 | ||||||||||
|---|---|---|---|---|---|---|---|---|---|---|---|---|
| WT | UBP2 | UBP14 | UBP2UBP14 | WT | UBP2 | UBP14 | UBP2UBP14 | WT | UBP2 | UBP14 | UBP2UBP14 | |
| Actin | 0.014672 | 0.022402 | 0.012201 | 0.027496 | 0.019134 | 0.023971 | 0.053691 | 0.023159 | 0.018671 | 0.023333 | 0.037331 | 0.024355 |
| Bud Neck | 0.089581 | 0.026844 | 0.008222 | 0.011286 | 0.059056 | 0.038455 | 0.017640 | 0.009944 | 0.062225 | 0.033737 | 0.013926 | 0.010314 |
| Bud Site | 0.216877* | 0.185860* | 0.147203* | 0.193382* | 0.167388* | 0.153435* | 0.212757* | 0.152712* | 0.172526* | 0.166611* | 0.186908* | 0.163930* |
| Cell Periphery | 0.110822* | 0.047187 | 0.009278 | 0.044200 | 0.080476 | 0.088486 | 0.044084 | 0.031723 | 0.083626 | 0.071704 | 0.030360 | 0.035164 |
| Cytoplasm | 0.428765* | 0.558189* | 0.657744* | 0.582273* | 0.545175* | 0.631270* | 0.593358* | 0.688762* | 0.533090* | 0.601574* | 0.618746* | 0.659390* |
| Cytoplasmic Foci | 0.030472 | 0.061595 | 0.064865 | 0.017197 | 0.033218 | 0.015201 | 0.011364 | 0.013651 | 0.032933 | 0.034053 | 0.032460 | 0.014629 |
| Eisosomes | 0.009509 | 0.003771 | 0.000176 | 0.000663 | 0.009602 | 0.009485 | 0.001927 | 0.000688 | 0.009592 | 0.007163 | 0.001237 | 0.000681 |
| Endoplasmic Reticulum | 0.019489 | 0.022286 | 0.010529 | 0.001686 | 0.016451 | 0.004711 | 0.002945 | 0.001840 | 0.016766 | 0.011852 | 0.005936 | 0.001797 |
| Endosome | 0.008288 | 0.010887 | 0.007667 | 0.002299 | 0.009402 | 0.002313 | 0.001761 | 0.002719 | 0.009287 | 0.005797 | 0.004090 | 0.002603 |
| Golgi | 0.010206 | 0.015849 | 0.008067 | 0.001936 | 0.010629 | 0.006712 | 0.001678 | 0.002991 | 0.010585 | 0.010425 | 0.004197 | 0.002700 |
| Lipid Particles | 0.004589 | 0.006949 | 0.022726 | 0.031030 | 0.004713 | 0.003145 | 0.014011 | 0.011519 | 0.004700 | 0.004691 | 0.017448 | 0.016900 |
| Mitochondria | 0.005544 | 0.003773 | 0.000177 | 0.001388 | 0.003071 | 0.003372 | 0.000241 | 0.001680 | 0.003328 | 0.003535 | 0.000216 | 0.001599 |
| Mitotic Spindle | 0.000070 | 0.002146 | 0.000806 | 0.001880 | 0.001432 | 0.000342 | 0.000128 | 0.000355 | 0.001291 | 0.001075 | 0.000395 | 0.000776 |
| None | 0.000057 | 0.000399 | 0.000430 | 0.000071 | 0.000063 | 0.000188 | 0.000160 | 0.000277 | 0.000063 | 0.000274 | 0.000266 | 0.000220 |
| Nuclear Periphery | 0.000084 | 0.000043 | 0.000034 | 0.000041 | 0.000047 | 0.000032 | 0.000035 | 0.000034 | 0.000051 | 0.000037 | 0.000035 | 0.000036 |
| Nuclear Periphery Foci | 0.000404 | 0.000653 | 0.005822 | 0.003391 | 0.000581 | 0.000181 | 0.001367 | 0.001781 | 0.000563 | 0.000372 | 0.003124 | 0.002225 |
| Nucleolus | 0.000044 | 0.000091 | 0.000057 | 0.000033 | 0.000036 | 0.000063 | 0.000038 | 0.000040 | 0.000037 | 0.000074 | 0.000045 | 0.000038 |
| Nucleus | 0.002323 | 0.002301 | 0.006407 | 0.002785 | 0.002713 | 0.002902 | 0.005554 | 0.002748 | 0.002672 | 0.002657 | 0.005890 | 0.002758 |
| Peroxisomes | 0.005163 | 0.007584 | 0.001853 | 0.002258 | 0.005201 | 0.006744 | 0.002193 | 0.002454 | 0.005197 | 0.007085 | 0.002059 | 0.002400 |
| Vacuole | 0.034894 | 0.018777 | 0.034568 | 0.074194 | 0.029763 | 0.008296 | 0.034683 | 0.049892 | 0.030296 | 0.012555 | 0.034638 | 0.056595 |
| Vacuole Periphery | 0.008148 | 0.002415 | 0.001168 | 0.000512 | 0.001850 | 0.000699 | 0.000385 | 0.001034 | 0.002503 | 0.001396 | 0.000694 | 0.000890 |
Localization Changes (T-score)
| R1 | R2 | R1 & R2 | |||||||||||||
|---|---|---|---|---|---|---|---|---|---|---|---|---|---|---|---|
| UBP2_WT | UBP14_WT | UBP2UBP14_WT | UBP2UBP14_UBP2 | UBP2UBP14_UBP14 | UBP2_WT | UBP14_WT | UBP2UBP14_WT | UBP2UBP14_UBP2 | UBP2UBP14_UBP14 | UBP2_WT | UBP14_WT | UBP2UBP14_WT | UBP2UBP14_UBP2 | UBP2UBP14_UBP14 | |
| Actin | -2.06 | 0.67 | -2.70 | -1.32 | -5.34 | -2.50 | -13.82 | -1.72 | 0.58 | 11.93 | -2.83 | -9.83 | -2.68 | -0.22 | 7.20 |
| Bud Neck | 3.31 | 4.30 | 4.15 | 9.53 | -3.39 | 4.73 | 10.25 | 12.19 | 16.15 | 9.31 | 6.67 | 11.73 | 12.63 | 18.79 | 6.08 |
| Bud Site | 0.97 | 2.23 | 0.92 | -0.09 | -3.88 | 1.52 | -4.82 | 1.73 | 0.36 | 9.03 | 0.68 | -1.57 | 1.28 | 1.01 | 4.48 |
| Cell Periphery | 2.98 | 4.80 | 3.26 | 1.29 | -7.82 | -1.22 | 6.08 | 8.22 | 15.38 | 4.45 | 1.95 | 9.32 | 8.53 | 13.22 | -1.72 |
| Cytoplasm | -4.20 | -7.37 | -4.71 | -1.59 | 5.56 | -7.24 | -3.87 | -11.50 | -6.06 | -10.54 | -6.30 | -7.70 | -10.81 | -7.30 | -5.29 |
| Cytoplasmic Foci | -3.16 | -3.60 | 1.17 | 12.44 | 15.35 | 6.69 | 8.00 | 6.81 | 0.58 | -1.73 | -0.38 | -0.06 | 6.53 | 11.03 | 11.62 |
| Eisosomes | 3.37 | 5.54 | 5.27 | 12.57 | -6.07 | 0.11 | 8.72 | 10.16 | 17.66 | 9.99 | 2.81 | 10.37 | 11.08 | 20.48 | 6.81 |
| Endoplasmic Reticulum | -0.30 | 0.99 | 1.97 | 8.31 | 6.63 | 4.27 | 4.99 | 5.36 | 3.90 | 1.93 | 1.75 | 4.12 | 5.76 | 8.95 | 6.27 |
| Endosome | -1.16 | 0.29 | 2.78 | 8.10 | 5.76 | 6.68 | 7.00 | 5.46 | -0.54 | -1.26 | 3.38 | 5.10 | 6.21 | 5.03 | 2.41 |
| Golgi | -2.34 | 1.01 | 3.68 | 10.99 | 6.67 | 3.52 | 11.40 | 7.76 | 3.58 | -1.70 | 0.14 | 8.51 | 9.17 | 9.28 | 2.56 |
| Lipid Particles | -1.94 | -9.80 | -8.62 | -8.21 | -2.52 | 2.50 | -9.15 | -6.07 | -7.66 | 1.69 | -0.02 | -13.78 | -10.25 | -10.60 | 0.35 |
| Mitochondria | 0.70 | 2.20 | 1.57 | 1.89 | -0.90 | -0.28 | 2.78 | 1.11 | 1.93 | -1.66 | -0.21 | 3.28 | 1.55 | 2.67 | -1.90 |
| Mitotic Spindle | -2.25 | -6.66 | -1.82 | 0.07 | -1.14 | 0.86 | 1.04 | 0.86 | -0.02 | -1.75 | 0.17 | 0.79 | 0.40 | 0.52 | -1.33 |
| None | -1.50 | -4.48 | -0.60 | 1.43 | 4.40 | -4.65 | -4.13 | -1.34 | -0.53 | -0.70 | -2.25 | -5.66 | -1.36 | 0.39 | 0.43 |
| Nuclear Periphery | 1.50 | 1.90 | 1.59 | -0.00 | -2.12 | 2.49 | 1.81 | 1.35 | -0.38 | 0.09 | 2.05 | 2.52 | 1.76 | -0.09 | -0.30 |
| Nuclear Periphery Foci | -1.15 | -12.36 | -12.28 | -9.58 | 4.81 | 4.14 | -6.22 | -6.25 | -9.06 | -2.08 | 1.63 | -12.91 | -10.24 | -11.58 | 3.56 |
| Nucleolus | -1.55 | -0.71 | 0.40 | 2.20 | 4.00 | -2.61 | -0.66 | -1.13 | 2.22 | -0.71 | -3.11 | -2.62 | -0.58 | 2.98 | 2.42 |
| Nucleus | 0.05 | -8.54 | -1.98 | -3.58 | 8.39 | -0.63 | -10.06 | -1.11 | -0.20 | 9.36 | 0.07 | -13.28 | -1.72 | -1.75 | 12.60 |
| Peroxisomes | -2.49 | 3.88 | 3.31 | 9.88 | -1.76 | -2.21 | 5.79 | 4.78 | 7.66 | -0.95 | -3.26 | 6.66 | 5.51 | 11.48 | -1.65 |
| Vacuole | 1.57 | -0.17 | -4.47 | -12.99 | -9.21 | 8.93 | -2.94 | -7.38 | -18.49 | -6.16 | 7.32 | -2.70 | -10.09 | -21.60 | -10.37 |
| Vacuole Periphery | 0.83 | 1.01 | 1.11 | 6.76 | 2.79 | 2.91 | 3.65 | 1.46 | -0.67 | -1.37 | 1.37 | 2.27 | 1.92 | 1.60 | -0.52 |
Endocytosis
| Temp | Actin Patch (Sac6-tdTomato) | Cortical Patch (Sla1-GFP) | Late Endosome (Snf7-GFP) | Vacuole (Vph1-GFP) |
|---|---|---|---|---|
| 37℃ | ||||
| RT |
Cell Cycle Omics
CYCLoPs (Rbl2-GFP)
| Gene / Allele | Actin Patch (Sac6-tdTomato) | Cortical Patch (Sla1-GFP) | Late Endosome (Snf7-GFP) | Vacuole (Sac6-tdTomato) |
|---|
| Gene | Images |
|---|
| Gene | Images |
|---|
Images are not yet available
Images are not yet available